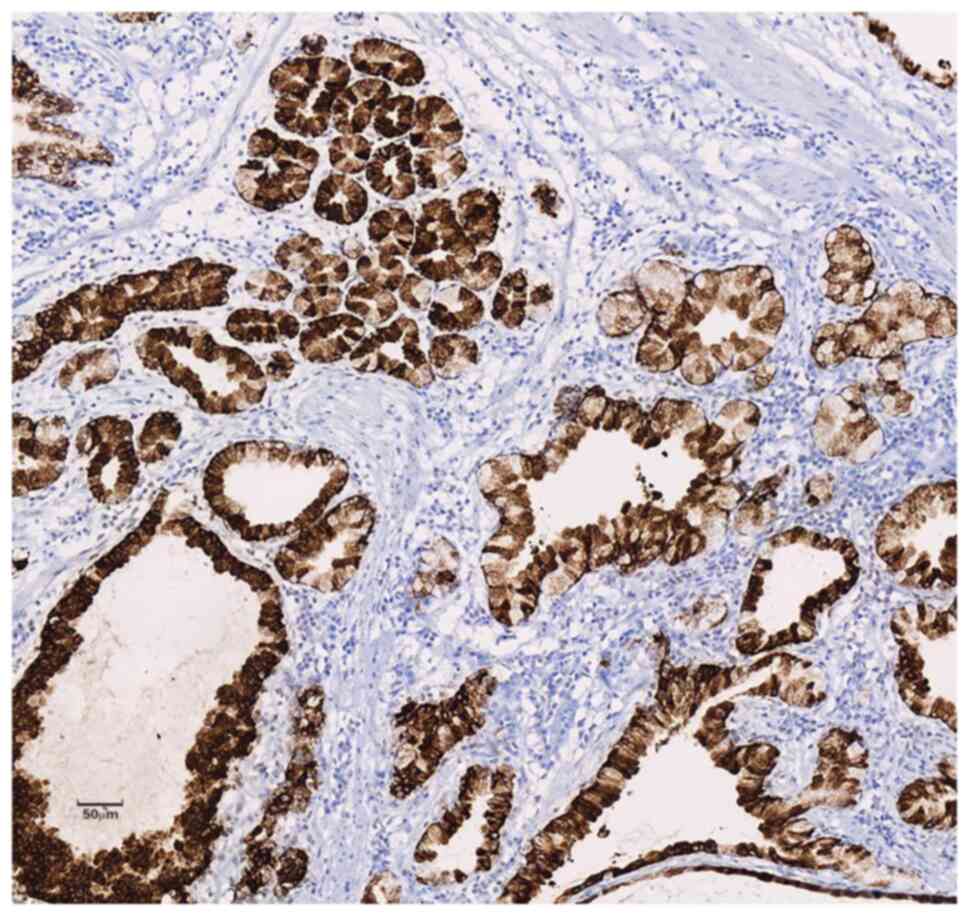

- About
-
Journals
- All Journals
- Oncology Letters
- International Journal of Oncology
- Molecular and Clinical Oncology
- Experimental and Therapeutic Medicine
- International Journal of Molecular Medicine
- Biomedical Reports
- Oncology Reports
- Molecular Medicine Reports
- World Academy of Sciences Journal
- International Journal of Functional Nutrition
- International Journal of Epigenetics
- Medicine International
- Articles
- Information
- Language Editing
- This site uses cookies
-
You can change your cookie settings at any time by following the instructions in our Cookie Policy. To find out more, you may read our Privacy Policy.
I agree